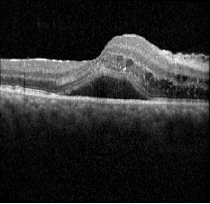
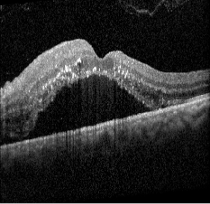

Severe Hypertensive Retinopathy
CASE STUDY: A 33-year-old Hispanic male is referred in for retinal hemorrhages, presenting blurry vision. Curtis Hagedorn, M.D., vitreoretinal specialist at Colorado Retina, delves into this unique case of severe hypertensive retinopathy, triggered by an unexpected factor that caused elevated blood pressure. Dr. Hagedorn takes us through the diagnostic process and key imaging findings that raised red flags, ultimately leading to a retinal diagnosis.
A 33-year-old Hispanic male was referred to Colorado Retina Associates with retinal hemorrhages and blurred vision, a concerning presentation for a generally healthy young man. His visual acuity was measured around 20/70 - 20/80 in both eyes. Fundus autofluorescence revealed similar findings in both eyes. In the left eye, the optic disc appeared slightly swollen with evident disc edema, along with vitreous exudates and swelling surrounded by cotton wool spots in the macula—microinfarcts of retinal tissue. The vessels displayed notable arteriovenous (AV) nicking, where the arteries compressed the veins at their crossing points. Autofluorescence also showed areas of hyperautofluorescence, correlating with localized exudative retinal detachments.


Ocular coherence tomography (OCT) images for both eyes revealed subretinal and intraretinal fluid, as well as hyperreflective material within the retina.

Given these findings, fluorescein angiography was ordered to explore a vascular cause. The imaging revealed retinal leakage in the macula and disc in the right eye, while the left eye showed more significant disc leakage along with spots of macular and retinal leakage.


Despite being a 33-year-old without significant medical history, further questioning revealed untreated high blood pressure. The patient had previously been diagnosed with hypertension and treated with medication, but after being incarcerated, he had stopped taking his medication. Three weeks prior to presentation, he had used methamphetamine, which can cause a dangerous spike in blood pressure, increasing the risk of heart attack, stroke, and vascular occlusion. We concluded that the retinal presentation was a result of his untreated hypertension combined with his recent drug use.
Further investigation revealed that his blood pressure was severely elevated—systolic readings in the 200s and diastolic readings in the 100s, consistent with malignant hypertension. This case emphasizes the importance of asking about systemic conditions, including high blood pressure, diabetes, and smoking history, when faced with similar retinal findings. If these risk factors are absent, it's crucial to inquire about drug use, particularly cocaine or methamphetamine. To avoid awkwardness, I explain to patients that we're ruling out other causes and trying to understand why their retina looks the way it does.
This case was classified as grade 4 hypertensive retinopathy, the most severe category, marked by AV nicking, hemorrhages, cotton wool spots, retinal exudates, disc edema, and papillitis. The patient was started on blood pressure medications and advised to follow up with his prescribing primary care physician (PCP). A return visit to the retina specialist was suggested for 4–6 weeks to monitor his condition, as there was a possibility that retinal treatment might be needed if the issue didn’t resolve with blood pressure management.
In many cases, controlling the underlying acute issue can lead to resolution of macular edema and retinal changes, improving the vision. However, if the patient develops neovascularization or persistent macular edema, they may require intravitreal anti-VEGF treatment or laser therapy.
When managing patients with similar retinal findings, it’s important to assess risk factors and symptoms. If the patient is asymptomatic and presenting only with blurry vision with retinal imaging suggestive of hypertensive retinopathy, they should be referred to a retina specialist and seen within one week. However, if the patient also exhibits symptoms of vascular occlusion, such as severe headache, chest pain, confusion, or altered mental status, they should be directed to the emergency room immediately.
